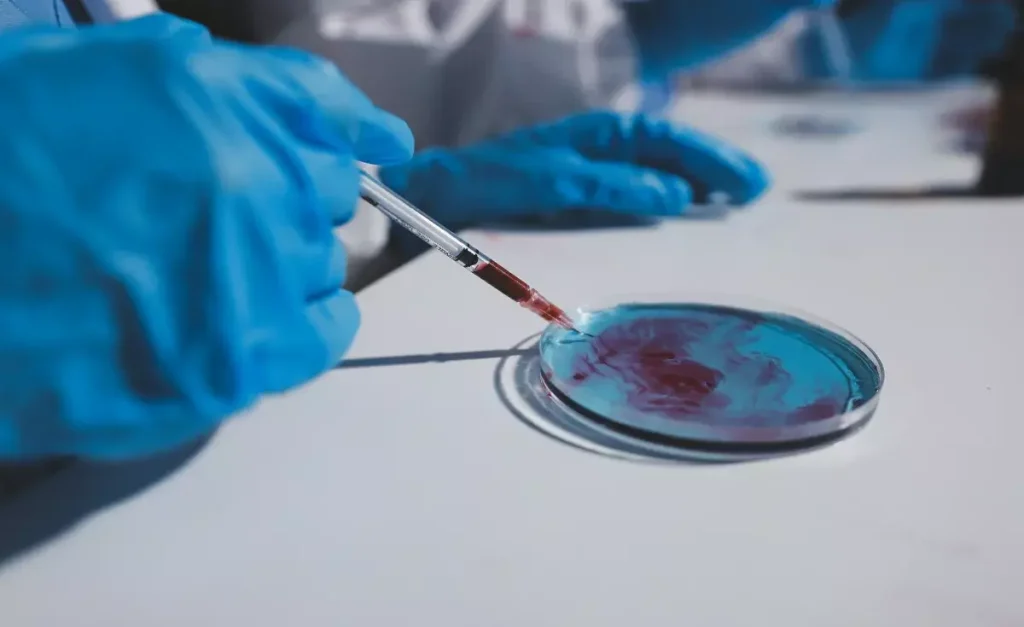
hsct stem cell transplant

Going through a hematopoietic stem cell transplantation (HSCT) is a big step. But with the right help, it can be a new start for many. At Liv Hospital, we’re here to help you every step of the way, making sure you get the best care.
HSCT has come a long way, starting in 1955. It’s now a key treatment for blood cancers and some immune problems. Our team is ready to support you, from the first check-up to after the transplant.
Getting ready for an HSCT can feel scary. This guide aims to make it easier. It covers the basics, the pre-transplant checks, and what happens during and after the transplant.
Key Takeaways
- Understanding the HSCT process and its significance in treating blood cancers and immune disorders.
- The importance of pre-transplant evaluation and preparation.
- What to expect during the HSCT procedure.
- Post-transplant care and recovery guidelines.
- The role of a dedicated healthcare team in supporting your HSCT journey.
Understanding Your HSCT Stem Cell Transplant

Starting a hematopoietic stem cell transplantation (HSCT) journey means learning a lot about it. This process uses healthy stem cells to fix your blood and immune system. It helps treat blood cancers and immune disorders.
What Is Hematopoietic Stem Cell Transplantation?
Hematopoietic stem cell transplantation, or bone marrow transplantation, is a treatment. It replaces your stem cells with healthy ones. This helps fix your blood and immune system if they’re damaged.
Research shows HSCT works well for many diseases. Knowing about HSCT helps patients get ready for treatment and what to expect.
Types of HSCT: Autologous vs. Allogeneic Transplants
There are two main types of HSCT: autologous and allogeneic. Autologous transplants use your own stem cells. They are collected, stored, and then put back in after treatment. This is often for cancer patients.
Allogeneic transplants use stem cells from someone else. Finding a good match is key to avoid complications. This type is for blood disorders or cancers not treatable with your own stem cells.
Conditions Treated with HSCT Therapy
HSCT therapy helps with blood cancers like leukemia and lymphoma. It also treats immune disorders like aplastic anemia.
Also, it’s used for metabolic diseases like Hurler syndrome. Knowing what HSCT can treat helps patients understand its benefits and risks.
Initial Consultation and Medical Evaluation
Getting ready for HSCT starts with an initial consultation. Here, patients talk with their transplant team about treatment options. They also go through medical tests needed for the transplant.
Finding the Right Transplant Center
Finding the right transplant center is key. It can greatly affect your HSCT’s success. Look for centers with experienced teams and good success rates.
When looking at transplant centers, check the team’s qualifications and patient care. Also, read patient testimonials and success stories to learn more about the center.
Required Medical Testing and Assessments
Medical tests and assessments are needed to check if you’re healthy enough for HSCT. These tests help find any health risks and make sure you’re ready for the transplant.
Tests like cardiac evaluations and lung function tests are important. They help figure out if you can handle the transplant.
Understanding Your Treatment Timeline
Knowing your treatment timeline is important for HSCT. It includes the initial consultation, pre-transplant prep, the transplant, and recovery. Understanding this helps you prepare mentally and logistically.
We help plan your treatment, including test schedules and the transplant date. This ensures you’re ready for each step.
Questions to Ask Your Transplant Team
It’s important to ask questions during your initial consultation. Ask about the transplant, risks, and what to expect during recovery.
We suggest writing down your questions. Open communication helps you feel supported and informed during your HSCT journey.
Building Your HSCT Support Network
Having a strong support network is key when preparing for HSCT. Studies show that those with a good support system do better and feel better during and after the transplant.
Identifying Your Primary Caregiver
Finding a primary caregiver is vital for daily help during the HSCT process. This person needs to be trustworthy, caring, and ready to handle big responsibilities.
Look for these qualities in a primary caregiver:
- Emotional stability and patience
- Ability to manage daily care tasks
- Good communication skills
- Willingness to learn about HSCT and its implications
Creating a Support Team Structure
A well-organized support team can make a big difference in your HSCT experience. This team might include family, friends, healthcare professionals, and others who have gone through HSCT.
Here’s how to build your support team:
- Figure out what help you need and what tasks need to be done
- Give each team member a role based on their skills and time
- Make sure everyone knows how to communicate with each other
Connecting with HSCT Patient Communities
Talking to other HSCT patients and survivors can offer valuable advice and emotional support. These communities let you share your story and learn from others who have been through the same thing.
Hospitals and transplant centers often have support groups for HSCT patients. Online forums and social media groups are also great places to connect with others.
Working with Hospital Social Workers
Hospital social workers are important for helping HSCT patients and their families. They can guide you through the healthcare system, help with financial issues, and support you emotionally.
If you need help, don’t be shy to contact your hospital’s social work department. They can create a support plan that fits your needs.
Financial and Logistical Planning for HSCT Stem Cell Transplant
Getting ready for a Hematopoietic Stem Cell Transplant (HSCT) is more than just medical prep. It also means looking at finances and making travel plans. Knowing the costs and making travel plans can really help your recovery.
Understanding Insurance Coverage and Limitations
First, check your insurance to see what’s covered. Look at your policy to see what’s included, like the transplant, hospital stay, and meds. It’s also important to know what’s not covered, like out-of-network care or certain treatments.
Key things to talk to your insurance about include:
- What’s covered for HSCT and related care
- Costs for out-of-network care
- Any special approvals needed for treatments
- How much you’ll have to pay out-of-pocket
Available Financial Assistance Programs
There are programs to help with HSCT costs. They can cover expenses, travel, and lodging. We suggest looking into these and talking to your transplant center about them.
Some financial help programs are:
- Patient advocacy groups
- Cancer foundations
- Government aid
Planning for Extended Time Away from Work
Plan for being out of work for a while after HSCT. Understand your job’s leave policies and look into disability benefits. Talk to your employer about your plans to make the transition easier.
By planning well for HSCT’s financial and travel needs, you can reduce stress. We’re here to help you through every step.
Pre-Transplant Medical Preparations
The journey to a successful HSCT stem cell transplant starts with careful pre-transplant medical preparations. These steps are key to keeping you safe and successful during the transplant.
Comprehensive Health Screening Requirements
Before the transplant, we do detailed health screenings. We look for any health issues that might affect the transplant. This includes blood tests, imaging studies, and heart checks.
Key Health Screening Tests:
- Blood tests to check your overall health and find infections
- Imaging studies (like X-rays and CT scans) to see how organs are working
- Heart evaluations (like echocardiograms) to check your heart health
Dental Work and Preventative Care
Dental care is a big part of getting ready for the transplant. We want you to have a dental check-up to find and fix any oral health problems. This helps avoid complications during the transplant.
Dental Care Checklist:
| Dental Procedure | Purpose | Timing |
|---|---|---|
| Teeth cleaning | Remove plaque and bacteria | Before transplant |
| Fillings or extractions | Fix cavities or remove bad teeth | Before transplant |
| Gum treatment | Manage gum disease | Before transplant |
Central Venous Catheter Placement
A central venous catheter (CVC) is put in before the transplant. It helps give you medicines, blood products, and stem cells. The procedure involves putting a catheter into a big vein in your neck or chest.
Fertility Preservation Options
If you’re of reproductive age, thinking about fertility before HSCT is important. We talk about options like sperm banking and egg freezing to help keep your fertility.
Fertility Preservation Methods:
- Sperm banking for male patients
- Egg freezing for female patients
- Embryo freezing for couples
By doing these pre-transplant steps, we can greatly improve your chances of a successful HSCT stem cell transplant.
Preparing Your Home Environment
To ensure a safe and healthy recovery, preparing your home is key before an HSCT stem cell transplant. Medical guidelines say patients need a clean, infection-free space to avoid complications.
Creating a Clean and Infection-Free Space
Keeping your home clean is vital to avoid infections. Clean your home thoroughly, focusing on areas you’ll use a lot during recovery. Dust, vacuum, and disinfect surfaces. A clean home is essential for HSCT patients, experts say.
Focus on your bedroom and bathroom, as you’ll use them most. Make sure bedding, towels, and personal items are clean and ready.
Essential Supplies to Stock
Having the right supplies can make recovery easier. You’ll need:
- Comfortable clothes and bedding
- Personal care items like toothbrushes, toothpaste, and soap
- Nutritional supplements and easy meals
- Medications and prescriptions
- Things to keep you entertained, like books or games
Having these supplies ready reduces the need for others to go out. This helps keep you safe from infections.
Home Modifications for Recovery
Some home changes can improve your recovery. Think about:
- Moving your bed to the ground floor if you have stairs
- Keeping your home well-ventilated and at a comfortable temperature
- Removing hazards to prevent falls
- Creating a quiet, comfortable space for rest
These changes can lessen physical strain and make your recovery space better.
Food Safety and Dietary Preparations
Food safety is important during recovery. Prepare meals in advance that are easy to reheat. Avoid foods that can easily get contaminated, like unpasteurized dairy or undercooked meats. “Good food safety is key to avoiding illnesses during recovery,” experts stress.
Have non-perishable items on hand and a reliable way to heat food. If you can, have someone help with meal prep.
The Stem Cell Collection Process
The success of an HSCT transplant depends a lot on the stem cell collection process. This process is key, involving careful planning and precise medical steps. It requires a deep understanding of each step involved.
Donor Selection and HLA Matching (For Allogeneic Transplants)
For allogeneic transplants, donor selection and HLA matching are very important. HLA (Human Leukocyte Antigen) matching helps lower the risk of graft-versus-host disease (GVHD). We work with the transplant team to find a good donor and do the HLA typing.
The process tests the donor’s HLA genes to check if they match the recipient. This match is key for the transplant’s success and the recipient’s health.
Stem Cell Mobilization Procedures
Stem cell mobilization gets stem cells from the bone marrow into the bloodstream. This is done with medicines that help release the stem cells.
We’ll help you through the mobilization process. This includes giving growth factors and checking your stem cell count to find the best time for collection.
What to Expect During Collection Day
On collection day, you’ll have a procedure called apheresis or leukapheresis. This removes blood, separates stem cells, and returns the rest of the blood to your body.
The process is usually okay, but we’ll get you ready for any side effects. We’ll make sure you’re comfortable during the procedure.
Recovery After Stem Cell Collection
After collection, you’ll be watched to make sure you’re okay. Some people might feel tired, have bone pain, or other side effects. We’ll take care of these with the right treatment.
We’ll also tell you how to take care of yourself after collection. This includes any follow-up visits and medicines to help you recover.
Conditioning Regimen and Hospital Admission
Getting ready for your Hematopoietic Stem Cell Transplant (HSCT) means learning about the conditioning regimen and hospital admission. The conditioning regimen gets your body ready for the transplant by destroying your old bone marrow. This makes room for the new stem cells.
Chemotherapy and Radiation Treatments
The conditioning regimen often includes chemotherapy and sometimes radiation therapy. Chemotherapy kills cancer cells and weakens your immune system. This helps prevent it from rejecting the new stem cells. Radiation therapy might be used to weaken your immune system further or target specific areas.
The specific conditioning regimen depends on your disease, health, and transplant type. Your healthcare team will explain the details to you.
Managing Side Effects During Conditioning
Handling side effects is key during the conditioning regimen. Common issues include nausea, fatigue, hair loss, and a higher risk of infections. Your healthcare team will give you medicines and support to manage these side effects.
- Medications to prevent nausea and vomiting
- Transfusions to support blood cell counts
- Antibiotics to prevent infections
It’s vital to follow your healthcare team’s advice and report any side effects. Working together, you can lessen these effects and get ready for your transplant.
What to Pack for Your Hospital Stay
Packing the right things for your hospital stay can greatly improve your comfort and recovery. You’ll need comfortable clothes, personal hygiene items, and anything that brings you comfort.
- Comfortable clothing and slippers
- Toiletries and personal hygiene items
- Books, magazines, or a tablet for entertainment
Remember to check with your hospital for any items they recommend or don’t allow.
Mental Preparation for Treatment Intensity
Mental preparation is as important as physical preparation. The conditioning regimen and transplant can be tough emotionally. Meditation, deep breathing, and staying in touch with loved ones can help.
“The mental preparation and support I received before my transplant made a huge difference in my ability to cope with the treatment.” – HSCT Patient
We suggest trying these techniques and building a support network for your journey.
Conclusion: Final Preparations for Transplant Day
As transplant day gets closer, it’s key to make final preparations for a successful hematopoietic stem cell transplantation (HSCT). We’ve walked you through the important steps to get ready for your HSCT stem cell transplant. This includes understanding the treatment and planning for transplant day.
It’s important to plan carefully to make the transplant process smooth. Medical guidelines suggest detailed preparation to handle side effects and complications. For more details on what to expect after an allogeneic stem cell transplant, check out Liv Hospital’s guide.
By following this guide, you’ll feel more ready and confident for your HSCT stem cell transplant. We’re here to support and care for you every step of the way. Our goal is to help you get the best results from your hematopoietic stem cell transplantation.
What is Hematopoietic Stem Cell Transplantation (HSCT)?
HSCT is a treatment that uses healthy stem cells to fix your blood and immune system. It helps with blood cancers, immune problems, and metabolic diseases.
What are the types of HSCT stem cell transplants?
There are two main types: autologous and allogeneic. Autologous uses your own stem cells. Allogeneic uses stem cells from a donor.
What is the difference between autologous and allogeneic HSCT?
Autologous HSCT uses your own stem cells. Allogeneic HSCT uses a donor’s stem cells. The choice depends on your health and donor availability.
What is involved in the initial consultation and medical evaluation for HSCT?
You’ll meet with your transplant team to discuss treatment. You’ll also have medical tests to see if you’re a good candidate.
How do I find the right transplant center for my HSCT?
We help you find a good transplant center. Look at the center’s experience, the team’s expertise, and the care quality.
What are the pre-transplant medical preparations required for HSCT?
You’ll need health screening, dental work, and a central venous catheter. You’ll also have options for fertility preservation.
How can I prepare my home environment for a safe and successful recovery?
We show you how to make your home safe and clean. You’ll need to stock up on supplies and make home modifications.
What is the stem cell collection process like?
For allogeneic transplants, you’ll need a donor and HLA matching. Then, stem cells are mobilized and collected. We explain what happens on collection day and after.
What is the conditioning regimen for HSCT, and what are the side effects?
Conditioning involves chemotherapy and/or radiation to prepare your body. We talk about managing side effects and getting ready for your hospital stay.
How can I manage the financial and logistical aspects of HSCT?
We help you understand insurance and estimate costs. We also look at financial help and plan for time off work.
What kind of support network should I have during HSCT?
Having a strong support network is key. This includes family, friends, and healthcare professionals for emotional and practical support.
What are the benefits of connecting with HSCT patient communities?
Joining patient communities offers emotional support and practical advice. It also connects you with others who have gone through similar experiences.
How can I prepare for the intensity of the HSCT treatment?
We teach you mental preparation techniques. This includes managing stress, anxiety, and other emotional challenges during treatment.
What is hematopoietic cell transplantation (HCT) and how does it relate to HSCT?
HCT is another name for HSCT. Both involve transplanting healthy stem cells to restore your blood and immune system.
What are the possible complications of HSCT?
Complications include graft-versus-host disease (GVHD), infections, and organ damage. We discuss these risks and how to manage them.
References
- Cancer Council Australia. “Steps in an Autologous Stem Cell Transplant. Retrieved from https://www.cancercouncil.com.au/non-hodgkin-lymphoma/treatment/peripheral-blood-stem-cell-transplant/steps-in-an-autologous-stem-cell-transplant/
- American Cancer Society. “Stem Cell Transplant Process. Retrieved from https://www.cancer.org/cancer/managing-cancer/treatment-types/stem-cell-transplant/process.html